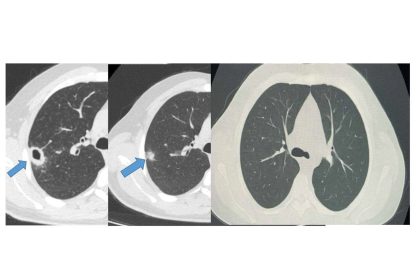
bayburtta-50-yasindaki-hasta-erken-taniyla-sagligina-kavustu

Erken teşhis için sokak lambaları pembe yanıyor
UEDAŞ, 2017 yılından bu yana Pembe Lambalar Projesi ile erken teşhisin hayati…
Meme kanserinde erken tanı, yüzde 99 hayat kurtarıyor
Meme Kanseri Farkındalık ayı dolayısıyla bilgilendirmede bulunan uzmanlar, erken teşhisin önemini hatırlatarak…
Meme kanserini erken teşhisle yendi, şimdi diğer kadınlara umut oluyor
Denizli’de 1 yıldır meme kanseriyle mücadele eden 41 yaşındaki Ayşegül Günbal, erken…
Çikolata kisti her 7 kadından 1’ini etkiliyor
Kadın Hastalıkları ve Doğum Uzmanı Dr. Hasan Can Toyganözü, endometriozisin doğurganlığı etkileyebildiğini…
Aydın’da meme kanserine dikkat çekildi
Aydın Devlet Hastanesi’nde düzenlenen ’Meme Kanseri Farkındalık Etkinliği’ ile erken teşhisin önemine…
40 yaş üstü kadınlara hayati uyarı: ‘Mamografi ihmal edilmemeli’
Atatürk Üniversitesi Tıp Fakültesi Genel Cerrahi Ana Bilim Dalı Öğretim Üyesi Prof.…
“Meme kanserinde farkındalık, erken teşhisin ilk adımı”
Meme kanserinin erken tanısının hayati önem taşıdığını belirten Genel Cerrahi Uzmanı Prof.…
“Erkeklerde de meme kanseri görülebilir”
Meme kanserinin yalnızca kadınlarda değil, erkeklerde de görülebileceğine dikkat çeken Plastik, Rekonstrüktif…
Bayburt’ta 50 yaşındaki hasta erken tanıyla sağlığına kavuştu
Bayburt Devlet Hastanesine öksürük ve balgam şikayetiyle başvuran 50 yaşındaki hastanın akciğerinde…
Meme kanserinde erken teşhiste radyolojinin gücü
Meme kanseri kadınlarda en sık görülen kanser türlerinden biri. Erken teşhis edildiğinde…